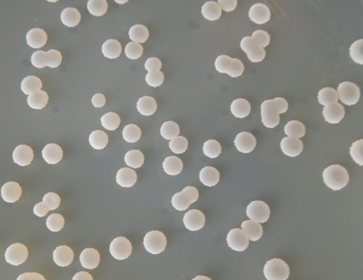
地衣芽孢桿菌

【主要成分】:地衣芽孢桿菌、載體保護劑。
【適用范圍】:適用于飼料添加和畜禽養殖 【活菌含量】:200億CFU/g、1000億CFU/g、2000億CFU/g、5000億CFU/g 【規格】:1kg/袋,25kg/袋 【訂購熱線】:15864568860(質優價廉、量大從優)
掃碼關注,獲取更多信息
現貨工廠直發,可定制,接受OEM/ODM客戶
誠招各地代理及經銷商!
歡迎來電咨詢 :秦經理:15864568860



【主要成分】地衣芽孢桿菌、載體保護劑。
【產品規格】200億CFU/g、1000億CFU/g、2000億CFU/g、5000億CFU/g。
【產品性狀】淺灰白色粉末。
【適用范圍】本品適用于飼料添加和畜禽養殖。
【使用說明】
飼料添加:逐級稀釋后直接添加到畜禽飼料中,以1000億CFU/g產品為例,每噸全價配合飼料中添加30-50g。(與枯草芽孢桿菌共同使用時,每種添加15-25g)
飲水:以1000億CFU/g產品為例,每噸飲水中添加10-20g。
【注意事項】
1、存放在避光、通風、干燥、無污染的地方,避免與有毒、有害物質混合存放;
2、原包裝打開后盡快使用,剩余部分需密封保存;
3、使用時避免吸入,防止與皮膚或粘膜接觸,若有接觸應立即用清水沖洗。
【保質期】在符合運輸、儲存條件的情況下,原包裝產品的保質期為12個月。
【包裝規格】每袋1kg、25 kg。
【圖片展示】
益昊生物公眾號
益昊生物小程序